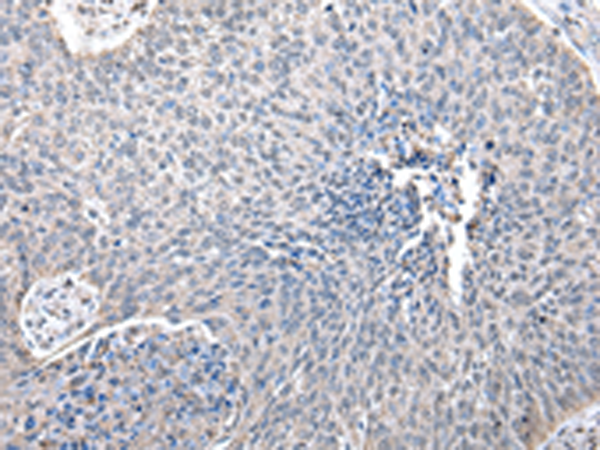
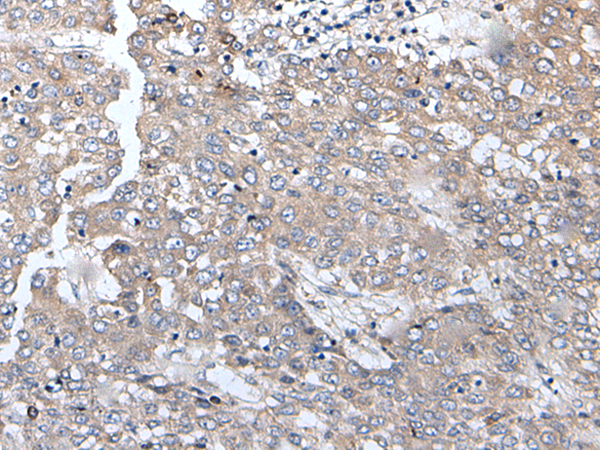
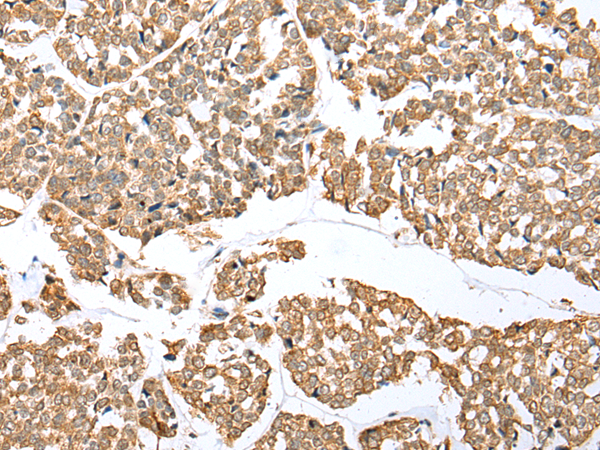
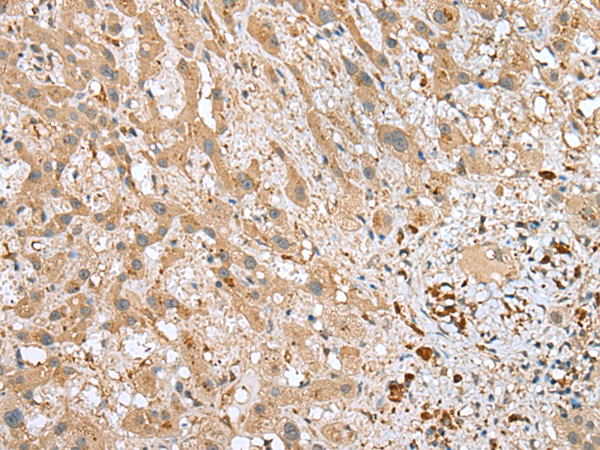
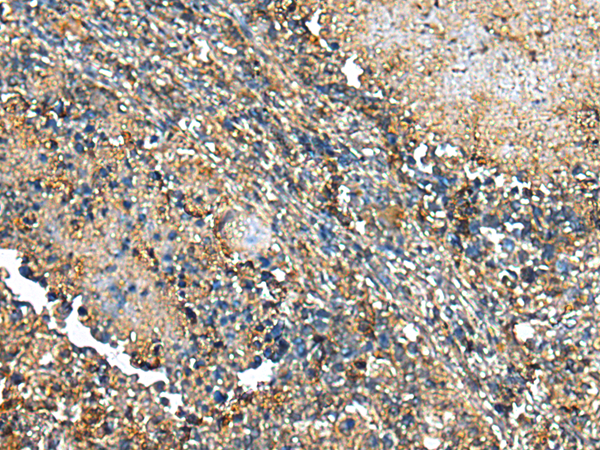
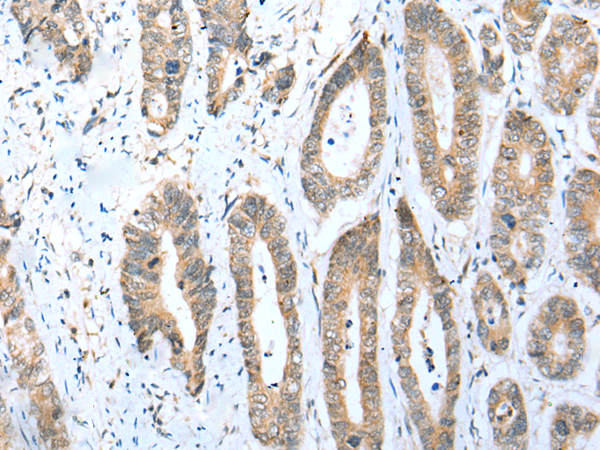

-
分类: 科研抗体货号: P09017别名: ZNF338应用: IHC反应种属: Human, Mouse
-
分类: 科研抗体货号: P09029别名: BRMS1应用: IHC反应种属: Human, Mouse
-
分类: 科研抗体货号: P09044别名: Dlc2; DNCL1B; RSPH22应用: IHC反应种属: Human, Mouse, Rat
-
分类: 科研抗体货号: P09043别名: ARF1P2; ARL17P1; ARL17; ARL17A应用: IHC反应种属: Human
-
分类: 科研抗体货号: P09034别名: B12; CI-B12应用: WB,IHC反应种属: Human
-
分类: 科研抗体货号: P09042别名: S21; HLDF应用: IHC反应种属: Human, Mouse, Rat
-
分类: 科研抗体货号: P09033别名: PDSW应用: WB,IHC反应种属: Human
-
分类: 科研抗体货号: P09040别名: F10应用: WB,IHC反应种属: Human, Mouse
-
分类: 科研抗体货号: P09062别名: HMFT0700应用: WB,IHC反应种属: Human
-
分类: 科研抗体货号: P09061别名: MDS009应用: IHC反应种属: Human

鄂公网安备42018502007531号
鄂公网安备42018502007531号

